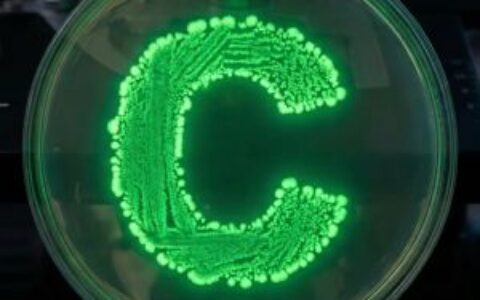
Axiom调查后：鲸鱼钱包在Polymarket引发内幕交易质疑

在针对阿根廷总统哈维尔·米莱(Javier Milei)推广的Libra代币的持续调查中,审查被扣押电子设备的专家发现了米莱与代币发行相关人士毛里西奥·诺维利(Mauricio Novelli)之间的通信记录。调查还发现,其他一些对话中的多条信息已被删除。

Libra调查持续进行:手机中发现被删除的通信记录
作为正在进行的Libra代币调查的一部分,法证专家对扣押的电子设备进行了审查。Libra代币是由阿根廷总统哈维尔·米莱推广的加密货币项目。调查人员在设备中检测到米莱与毛里西奥·诺维利之间的通信,诺维利是与该代币发行相关的个人之一。
值得注意的是,专家发现其他对话中的多条信息已被删除,这增加了调查的复杂性。目前调查仍在继续,当局正在分析已恢复的数据以获取更多证据。
此案引起了加密货币社区的广泛关注,因为它涉及国家元首与加密货币项目的直接关联。阿根廷作为拉丁美洲重要的加密货币市场,此案的进展可能对该地区的加密货币监管产生深远影响。
本网站所有区块链相关数据与资料仅供用户学习及研究之用,不构成任何投资建议。转载请注明出处:https://admin.chainnewclub.com/2026/02/28/libra%e6%a1%88%e6%96%b0%e8%bf%9b%e5%b1%95%ef%bc%9a%e6%b3%95%e8%af%81%e9%89%b4%e5%ae%9a%e5%8f%91%e7%8e%b0%e6%80%bb%e7%bb%9f%e7%b1%b3%e8%8e%b1%e6%b6%89%e6%a1%88%e4%bf%a1%e6%81%af%ef%bc%8c%e9%83%a8/